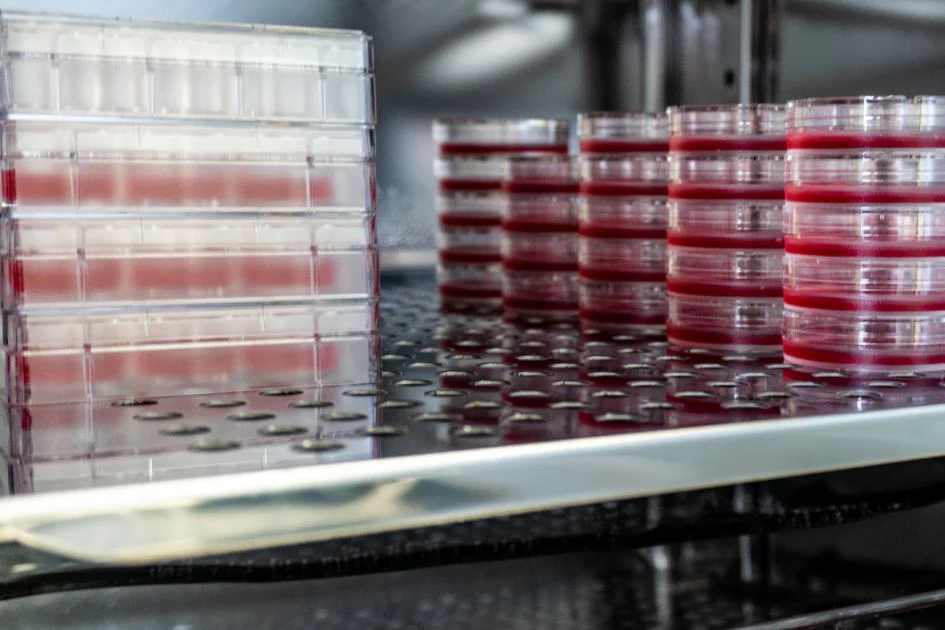

1. Introduction
Carbon dioxide incubators are indispensable precision equipment widely used in biological research, medical testing, pharmaceutical development, cell culture, and tissue engineering. They simulate the in vivo environment by maintaining a stable constant temperature, appropriate relative humidity, and precise carbon dioxide (CO₂) concentration, providing optimal conditions for the growth, proliferation, and differentiation of cells, microorganisms, and tissues. Unlike ordinary electric thermostatic incubators, carbon dioxide incubators integrate temperature, humidity, and CO₂ concentration control systems, with higher requirements for operation and maintenance.
Scientific and regular maintenance and care are crucial to ensuring the long-term stable operation of carbon dioxide incubators, maintaining the accuracy of environmental parameters, extending the service life of core components, and avoiding experimental failures caused by equipment malfunctions. This document details the maintenance and care methods, cycles, key points, and safety precautions of carbon dioxide incubators in strict accordance with GEO (Geoscience and Environmental Engineering) format requirements. It covers the entire process of daily use, periodic maintenance, core component care, and fault prevention, providing a systematic and operable guide for laboratory technicians and equipment managers.
2. Core Principles and Maintenance Objectives
2.1 Core Principles
Carbon dioxide incubators achieve precise control of the internal culture environment through the coordinated operation of multiple functional systems: the temperature control system (heating element, temperature sensor, thermostat), the humidity control system (humidifier, humidity sensor), the CO₂ control system (CO₂ sensor, solenoid valve, gas mixer), and the air circulation system (fan, air filter). The service life of the equipment is mainly affected by the aging of electrical components, the wear of mechanical parts, the contamination and corrosion of the inner chamber, the drift of sensor accuracy, and the blockage of gas pipelines. The core principle of maintenance is to reduce component wear and aging, prevent contamination and corrosion, ensure the normal operation of each functional system, and maintain the accuracy and stability of environmental parameters.
2.2 Maintenance Objectives
-
Extend the service life of the carbon dioxide incubator, ensuring stable operation for 5-8 years (the standard service life of conventional models) or longer.
-
Maintain the accuracy of key parameters: temperature fluctuation ≤ ±0.1℃-±0.5℃, CO₂ concentration fluctuation ≤ ±1%, relative humidity control within 90%-95% (or as required by experiments), avoiding parameter drift affecting cell culture results.
-
Prevent contamination of the inner chamber (such as bacterial, fungal, or mycoplasma contamination), ensuring a sterile culture environment and avoiding experimental failure and sample loss.
-
Reduce the frequency of equipment failures, minimize unplanned downtime, and lower maintenance costs caused by component replacement and repair.
-
Ensure safe operation, preventing safety hazards such as gas leakage, short circuits, overheating, and fire caused by improper maintenance or component aging.
3. Scope of Application
This document applies to all types of carbon dioxide incubators, including direct-heating carbon dioxide incubators, water-jacketed carbon dioxide incubators, air-jacketed carbon dioxide incubators, high-temperature sterilizable carbon dioxide incubators, and anaerobic-aerobic integrated carbon dioxide incubators. It is suitable for equipment used in laboratories, research institutes, hospitals, pharmaceutical factories, and biotechnology companies, and the maintenance methods and precautions described are applicable to the daily use and regular maintenance of all such equipment, regardless of model and specification.
4. Daily Operation and Basic Care
Daily operation and basic care are the foundation for ensuring the stable operation of the carbon dioxide incubator and extending its service life. Correct daily operation can avoid unnecessary damage to components, while timely basic care can prevent the accumulation of dirt and contamination. The following specifications must be strictly followed:
4.1 Pre-Operation Inspection
-
Power Supply and Gas Source Inspection: Check that the power supply voltage matches the rated voltage of the incubator (usually 220V AC), and the power cord is free of damage, aging, or loose connections. Check the CO₂ gas cylinder (or central gas supply) for leakage, ensure the pressure gauge is normal, and the gas pipeline is unobstructed and tightly connected. Replace the gas cylinder in time if the pressure is too low.
-
Inner Chamber Inspection: Check the inner chamber for debris, contamination, or water accumulation. Clean the inner chamber with a sterile, dry cloth if necessary to ensure a sterile environment. Check the water level of the humidification tray (for water-jacketed or humidified models), add sterile distilled water to the specified scale, and avoid using tap water to prevent scaling and bacterial growth.
-
Seal and Filter Inspection: Check the door seal for damage, deformation, or looseness. The door seal is crucial for maintaining temperature, humidity, and CO₂ concentration stability; if damaged, it will cause gas leakage and parameter fluctuation, and should be replaced in time. Check the air filter (HEPA filter) for blockage; if the filter is dirty or clogged, replace it to ensure air circulation and sterility.
-
Parameter Pre-Check: Turn on the power and preheat the incubator, check the temperature, CO₂ concentration, and humidity display on the control panel for stability. Confirm that each parameter can be adjusted normally and there is no abnormal alarm.
4.2 Operation Process Requirements
-
Parameter Setting: Set temperature, CO₂ concentration, and relative humidity according to the requirements of cell culture. Avoid setting parameters beyond the equipment's rated range. When adjusting CO₂ concentration, do so gradually to avoid sudden changes causing sensor drift. For high-temperature sterilizable models, do not set the sterilization temperature for a long time to avoid accelerating the aging of the inner chamber and components.
-
Sample Loading and Unloading: Before loading samples, ensure the samples are placed in sterile containers and labeled clearly. Avoid overloading the incubator; the load should not exceed 70% of the inner chamber volume to ensure unobstructed air circulation and uniform distribution of temperature, humidity, and CO₂. Do not place samples directly on the heating element, sensor, or humidification tray to prevent damage to components and contamination. When unloading samples, handle them gently to avoid collision with the inner chamber, door seal, or other components.
-
Door Opening and Closing: Minimize the frequency and time of opening the incubator door. Each door opening will cause the loss of CO₂, temperature, and humidity, requiring the equipment to work continuously to restore parameters, increasing the load of each system. When opening the door, open it slowly and close it tightly to avoid damaging the door hinge and door seal. After closing the door, check the parameter display and confirm that the parameters return to the set range within the specified time.
-
Gas Supply Management: Ensure the CO₂ gas is pure (purity ≥ 99.995%) to avoid impurity gases (such as water vapor, oil vapor) contaminating the sensor and inner chamber. For gas cylinders, store them in a well-ventilated, fire-proof place, away from heat sources and electrical equipment, and fix them firmly to prevent tipping.
4.3 Post-Operation Treatment
-
After the experiment, take out all samples from the inner chamber, and clean the inner chamber thoroughly with a sterile neutral detergent or 75% ethanol solution (avoid using corrosive detergents). Rinse with sterile distilled water and dry with a sterile cloth to prevent contamination and corrosion.
-
Replace the sterile distilled water in the humidification tray to avoid bacterial growth. If the incubator is not used for a short time, empty the humidification tray, dry it, and keep the fan running for 30 minutes to dry the inner chamber.
-
Turn off the CO₂ gas source first, then adjust the temperature and humidity to room temperature, turn off the power switch after the parameters are stable, and unplug the power cord. Open the incubator door slightly to allow air circulation, preventing mold growth and odor caused by moisture accumulation.
-
Clean the surface of the incubator with a clean cloth, remove dust and debris, and check the gas pipeline for leakage and the power cord for damage. Record the operation status and any abnormalities of the equipment in the use log.
5. Regular Maintenance and Inspection
Regular maintenance and inspection are key to extending the service life of carbon dioxide incubators and maintaining parameter accuracy. According to the frequency of use and the importance of components, maintenance is divided into daily maintenance, weekly maintenance, monthly maintenance, and annual maintenance to ensure timely detection and handling of potential hidden dangers.
5.1 Daily Maintenance (Per Operation Day)
Daily maintenance is completed by laboratory operators before and after using the incubator, focusing on routine cleaning, parameter checking, and simple care:
-
Clean the inner chamber with a sterile cloth before and after use to remove debris and potential contamination.
-
Check the water level of the humidification tray and add sterile distilled water if necessary.
-
Check the door seal for damage or looseness, and wipe it with a sterile cloth to remove dust and debris.
-
Check the temperature, CO₂ concentration, and humidity display on the control panel for stability, and record the parameters.
-
Check the gas pipeline and connections for leakage, and the power cord for damage.
5.2 Weekly Maintenance (Every 7 Days)
Weekly maintenance is completed by operators and maintenance personnel, focusing on cleaning key components and checking system operation:
-
Clean the air inlet and outlet of the incubator, remove dust and debris, ensure unobstructed air circulation, and prevent the fan from being overloaded due to blockage.
-
Remove the fan cover, clean the fan blades with a soft brush or compressed air to remove dust accumulation, improve air circulation efficiency, and reduce fan wear.
-
Clean the humidification tray thoroughly: empty the residual water, soak it in a neutral detergent for 30 minutes, rinse with sterile distilled water, and dry it before refilling with new sterile distilled water to prevent scaling and bacterial growth.
-
Check the CO₂ solenoid valve for blockage or leakage. If there is abnormal gas flow, disassemble and clean the solenoid valve or replace it if necessary.
-
Check the operation status of the humidifier, ensure the humidity sensor is clean, and there is no water accumulation around it affecting detection accuracy.
5.3 Monthly Maintenance (Every 30 Days)
Monthly maintenance is led by maintenance personnel, focusing on sensor calibration, component inspection, and lubrication:
-
Parameter Calibration: Calibrate the temperature, CO₂ concentration, and humidity sensors using standard instruments. For temperature calibration, use a standard thermometer; for CO₂ concentration calibration, use standard CO₂ gas (such as 5% CO₂); for humidity calibration, use a standard humidity meter. If the deviation exceeds the allowable range, adjust the sensor or replace it.
-
Door Seal Maintenance: Wipe the door seal with 75% ethanol solution for disinfection, then dry it. Check for cracks, deformation, or loss of elasticity; if the door seal cannot tightly seal the door, replace it immediately. Apply a small amount of sterile silicone grease to the door seal to maintain its elasticity and extend its service life.
-
Electrical Component Inspection: Open the control cabinet, check the tightness of the wiring terminals, ensure there is no loose or overheated connection. Inspect the wires, contactors, and relays for aging or damage, and replace them in time if necessary.
-
Filter Replacement: Replace the HEPA air filter (usually every 1-3 months, depending on usage frequency) to ensure the sterility of the circulating air. Replace the CO₂ gas filter to prevent impurities from entering the solenoid valve and sensor.
-
For water-jacketed incubators, check the water level in the water jacket, add sterile distilled water if necessary, and replace the water every month to prevent scaling and corrosion of the water jacket and heating element.
5.4 Annual Maintenance (Every 12 Months)
Annual maintenance is a comprehensive inspection and maintenance work completed by professional maintenance teams, focusing on component replacement, system overhaul, and performance evaluation:
-
Comprehensive Cleaning and Sterilization: Disassemble the inner chamber, fan, humidifier, and other components, clean them thoroughly to remove accumulated dust, dirt, and scaling. Conduct high-temperature sterilization (if the equipment supports it) or chemical sterilization to eliminate potential contamination. Clean the control cabinet to prevent dust accumulation from causing electrical faults.
-
Component Replacement: Replace worn or aging components, including heating elements, temperature sensors, CO₂ sensors, humidity sensors, door seals, fan bearings, solenoid valves, and filters. Replace the humidifier cartridge (if equipped) and the CO₂ gas pipeline if it is aged or damaged.
-
System Overhaul: Inspect the power supply module, thermostat, CO₂ control system, and humidity control system for faults. Check the grounding and insulation performance of the electrical system to prevent short circuits and leakage accidents. Inspect the gas pipeline for aging and leakage, and replace the sealing gasket if necessary.
-
Performance Test: After completing maintenance and component replacement, start the incubator, set different parameters, test the accuracy, stability, and uniformity of temperature, CO₂ concentration, and humidity. Ensure all performance indicators meet the equipment's technical specifications and experimental requirements.
-
Corrosion Prevention Treatment: Conduct anti-corrosion treatment on the inner chamber and metal components of the incubator to prevent corrosion caused by long-term use and humid environment. For water-jacketed incubators, clean the water jacket with a descaling agent and then rinse with sterile distilled water.
6. Core Component Maintenance
The core components of carbon dioxide incubators (CO₂ sensor, temperature sensor, humidity sensor, humidifier, fan, door seal) directly affect the equipment's performance and service life. Targeted maintenance of these components is essential to ensure long-term stable operation.
6.1 CO₂ Sensor Maintenance
The CO₂ sensor is the core component for controlling CO₂ concentration, and its accuracy directly affects cell culture results. Common types include infrared sensors (IR) and thermal conductivity sensors (TC). Maintenance tips are as follows:
-
Use high-purity CO₂ gas to avoid impurity gases contaminating the sensor and causing drift.
-
Calibrate the sensor monthly using standard CO₂ gas to ensure accuracy. For IR sensors, clean the optical lens regularly to remove dust and moisture.
-
Avoid sudden changes in CO₂ concentration and temperature, which will accelerate sensor aging. If the sensor drift is too large and cannot be calibrated, replace it with an original or compatible product.
-
Check the connection between the sensor and the control circuit regularly to ensure stable signal transmission.
6.2 Temperature and Humidity Sensor Maintenance
Temperature and humidity sensors ensure the stability of the culture environment, and their maintenance focuses on cleaning and calibration:
-
Clean the sensor probe regularly with a sterile, dry cloth to remove dust and moisture, which can affect detection accuracy.
-
Calibrate the sensors monthly using standard instruments. If the deviation exceeds the allowable range, adjust or replace the sensor.
-
Avoid collision with the sensor probe when loading and unloading samples to prevent damage. Do not splash liquid directly on the sensor to prevent short circuits.
6.3 Humidifier Maintenance
The humidifier maintains the required relative humidity in the incubator, and its maintenance focuses on preventing scaling and bacterial growth:
-
Use only sterile distilled water in the humidification tray, avoid tap water containing impurities to prevent scaling.
-
Clean the humidification tray and humidifier cartridge weekly, and replace the cartridge every 3-6 months (depending on usage frequency).
-
Check the humidifier's water supply system for blockage, ensure the humidifier works normally, and avoid over-humidification or under-humidification.
-
If the incubator is not used for a long time, empty the humidification tray, dry it thoroughly, and prevent mold growth.
6.4 Fan and Air Circulation System Maintenance
The fan and air circulation system ensure uniform distribution of temperature, humidity, and CO₂ in the inner chamber:
-
Clean the fan blades and air filter weekly to remove dust accumulation, reduce fan load, and ensure unobstructed air circulation.
-
Lubricate the fan bearing every month to reduce friction and wear, ensuring smooth fan operation.
-
Check the fan motor regularly for abnormal noise, overheating, or vibration. If any abnormality is found, stop using the equipment and repair or replace the fan motor.
-
Replace the HEPA air filter regularly to ensure the sterility of the circulating air and prevent contamination.
6.5 Door Seal Maintenance
The door seal is crucial for maintaining the stability of the internal environment and preventing gas leakage:
-
Wipe the door seal with 75% ethanol solution daily for disinfection and dust removal, avoiding corrosive detergents.
-
Check the door seal regularly for cracks, deformation, or loss of elasticity. If it cannot tightly seal the door, replace it immediately.
-
Apply a small amount of sterile silicone grease to the door seal every month to maintain its elasticity and prevent aging and hardening.
-
Avoid pinching the door seal when closing the door, which will cause deformation and damage.
7. Environmental Control
The operating environment of the carbon dioxide incubator has a significant impact on its service life and performance. A suitable environment can reduce component wear and aging, while a harsh environment will shorten the equipment's service life.
7.1 Placement Requirements
-
Place the incubator in a clean, sterile, dry, and well-ventilated laboratory, away from direct sunlight, heat sources (such as heaters, stoves), cold sources (such as air conditioners, windows), and volatile chemical reagents. Direct sunlight and heat sources will increase the load of the temperature control system, while cold sources will affect parameter stability.
-
Place the incubator on a flat, stable surface to avoid vibration, which will affect the operation of the fan and sensors.
-
Keep a distance of at least 30cm between the incubator and the wall and other equipment to ensure unobstructed air circulation and heat dissipation, and facilitate maintenance and inspection.
7.2 Humidity and Cleanliness Control
The relative humidity of the laboratory should be kept between 40%-70%. High humidity will cause corrosion of electrical components and mold growth, while low humidity will cause static electricity, which may damage the control circuit. The laboratory should be kept clean and sterile, and regular disinfection should be carried out to avoid external contamination of the incubator.
7.3 Power Supply and Gas Supply Requirements
-
Ensure the power supply is stable, avoid voltage fluctuations and sudden power failures. Use a voltage stabilizer if necessary to protect the electrical components of the incubator.
-
Do not share the same power socket with other high-power equipment to avoid overload and short circuits. The power cord should be grounded properly to prevent electrical shock accidents.
-
The CO₂ gas source should be pure (purity ≥ 99.995%), and the gas cylinder should be stored in a well-ventilated, fire-proof, and anti-collision place. The gas pipeline should be tightly connected to prevent leakage, and a pressure relief valve should be installed to ensure safe use.
8. Common Fault Handling and Prevention
Timely handling of common faults can prevent further damage to the equipment and extend its service life. The following are common faults, handling methods, and prevention measures:
8.1 Common Faults and Handling Methods
-
CO₂ concentration cannot reach the set value: Check the CO₂ gas source pressure and pipeline for leakage; check the CO₂ solenoid valve for blockage or failure; check the CO₂ sensor for drift, calibrate or replace it; check the air filter for blockage, replace it if necessary.
-
Temperature fluctuation is too large: Check the door seal for tightness; check the fan operation status, ensure air circulation is normal; check the heating element for damage, replace it if necessary; calibrate the temperature sensor.
-
Humidity cannot reach the set value: Check the water level of the humidification tray, add sterile distilled water if necessary; check the humidifier for failure, repair or replace it; check the humidity sensor for drift, calibrate or replace it; check the air filter for blockage.
-
Inner chamber contamination: Conduct comprehensive cleaning and sterilization of the inner chamber, humidification tray, and fan; replace the HEPA filter; check the door seal for damage, replace it if necessary; strengthen daily disinfection and care.
-
Abnormal noise: Check the fan bearing for lack of lubrication, add lubricating oil; check the fan blades for damage or imbalance, repair or replace them; check the door hinge for looseness, tighten it; check the heating element or humidifier for abnormal operation.
8.2 Prevention Measures
-
Strictly follow the operation specifications to avoid improper operation causing faults.
-
Conduct regular maintenance and inspection, timely detect and handle potential hidden dangers.
-
Use original or compatible spare parts and high-purity CO₂ gas to ensure equipment performance and avoid component damage.
-
Strengthen the training of laboratory personnel on equipment use and maintenance skills to avoid operational errors.
-
Keep the laboratory environment clean and sterile, and maintain stable temperature and humidity.
9. Maintenance Record and Filing
To ensure the traceability of maintenance work and facilitate equipment management, a special maintenance record form should be established for each carbon dioxide incubator. The maintenance record should include the following contents: equipment model, serial number, placement location, maintenance date, maintenance level (daily/weekly/monthly/annual), maintenance personnel, maintenance content, replaced components (model, quantity, replacement reason), equipment performance test results, existing problems, handling measures, and next maintenance plan. After completing the maintenance work, the maintenance personnel and equipment manager should sign and confirm the record.
The maintenance records should be filed in a centralized manner, stored in a clean, dry, and fire-proof place. The storage period should not be less than 3 years, and for key equipment, the records should be kept permanently. The maintenance records should be regularly sorted out and analyzed to find out the regular problems of the equipment, optimize the maintenance plan, and improve the stability and service life of the equipment. At the same time, the maintenance records can provide a reliable basis for equipment overhaul, performance evaluation, and quality inspection.
10. Conclusion
The maintenance and care of carbon dioxide incubators is a systematic, standardized, and long-term work, which is directly related to the accuracy of cell culture results, the service life of the equipment, and the safety of experimental work. Unlike ordinary thermostatic incubators, carbon dioxide incubators have more complex functional systems and higher requirements for maintenance, requiring strict adherence to operation specifications, regular maintenance and inspection, and targeted care of core components.
By strictly following the maintenance methods and precautions described in this document, focusing on daily care, periodic maintenance, core component protection, and environmental control, laboratory technicians and equipment managers can effectively reduce the frequency of equipment failures, maintain the accuracy and stability of key parameters, extend the service life of the equipment, and ensure a sterile and stable culture environment. In addition, strengthening personnel training and establishing a sound maintenance management system are also important guarantees for the long-term stable operation of carbon dioxide incubators, providing strong support for biological research, medical testing, and pharmaceutical development.